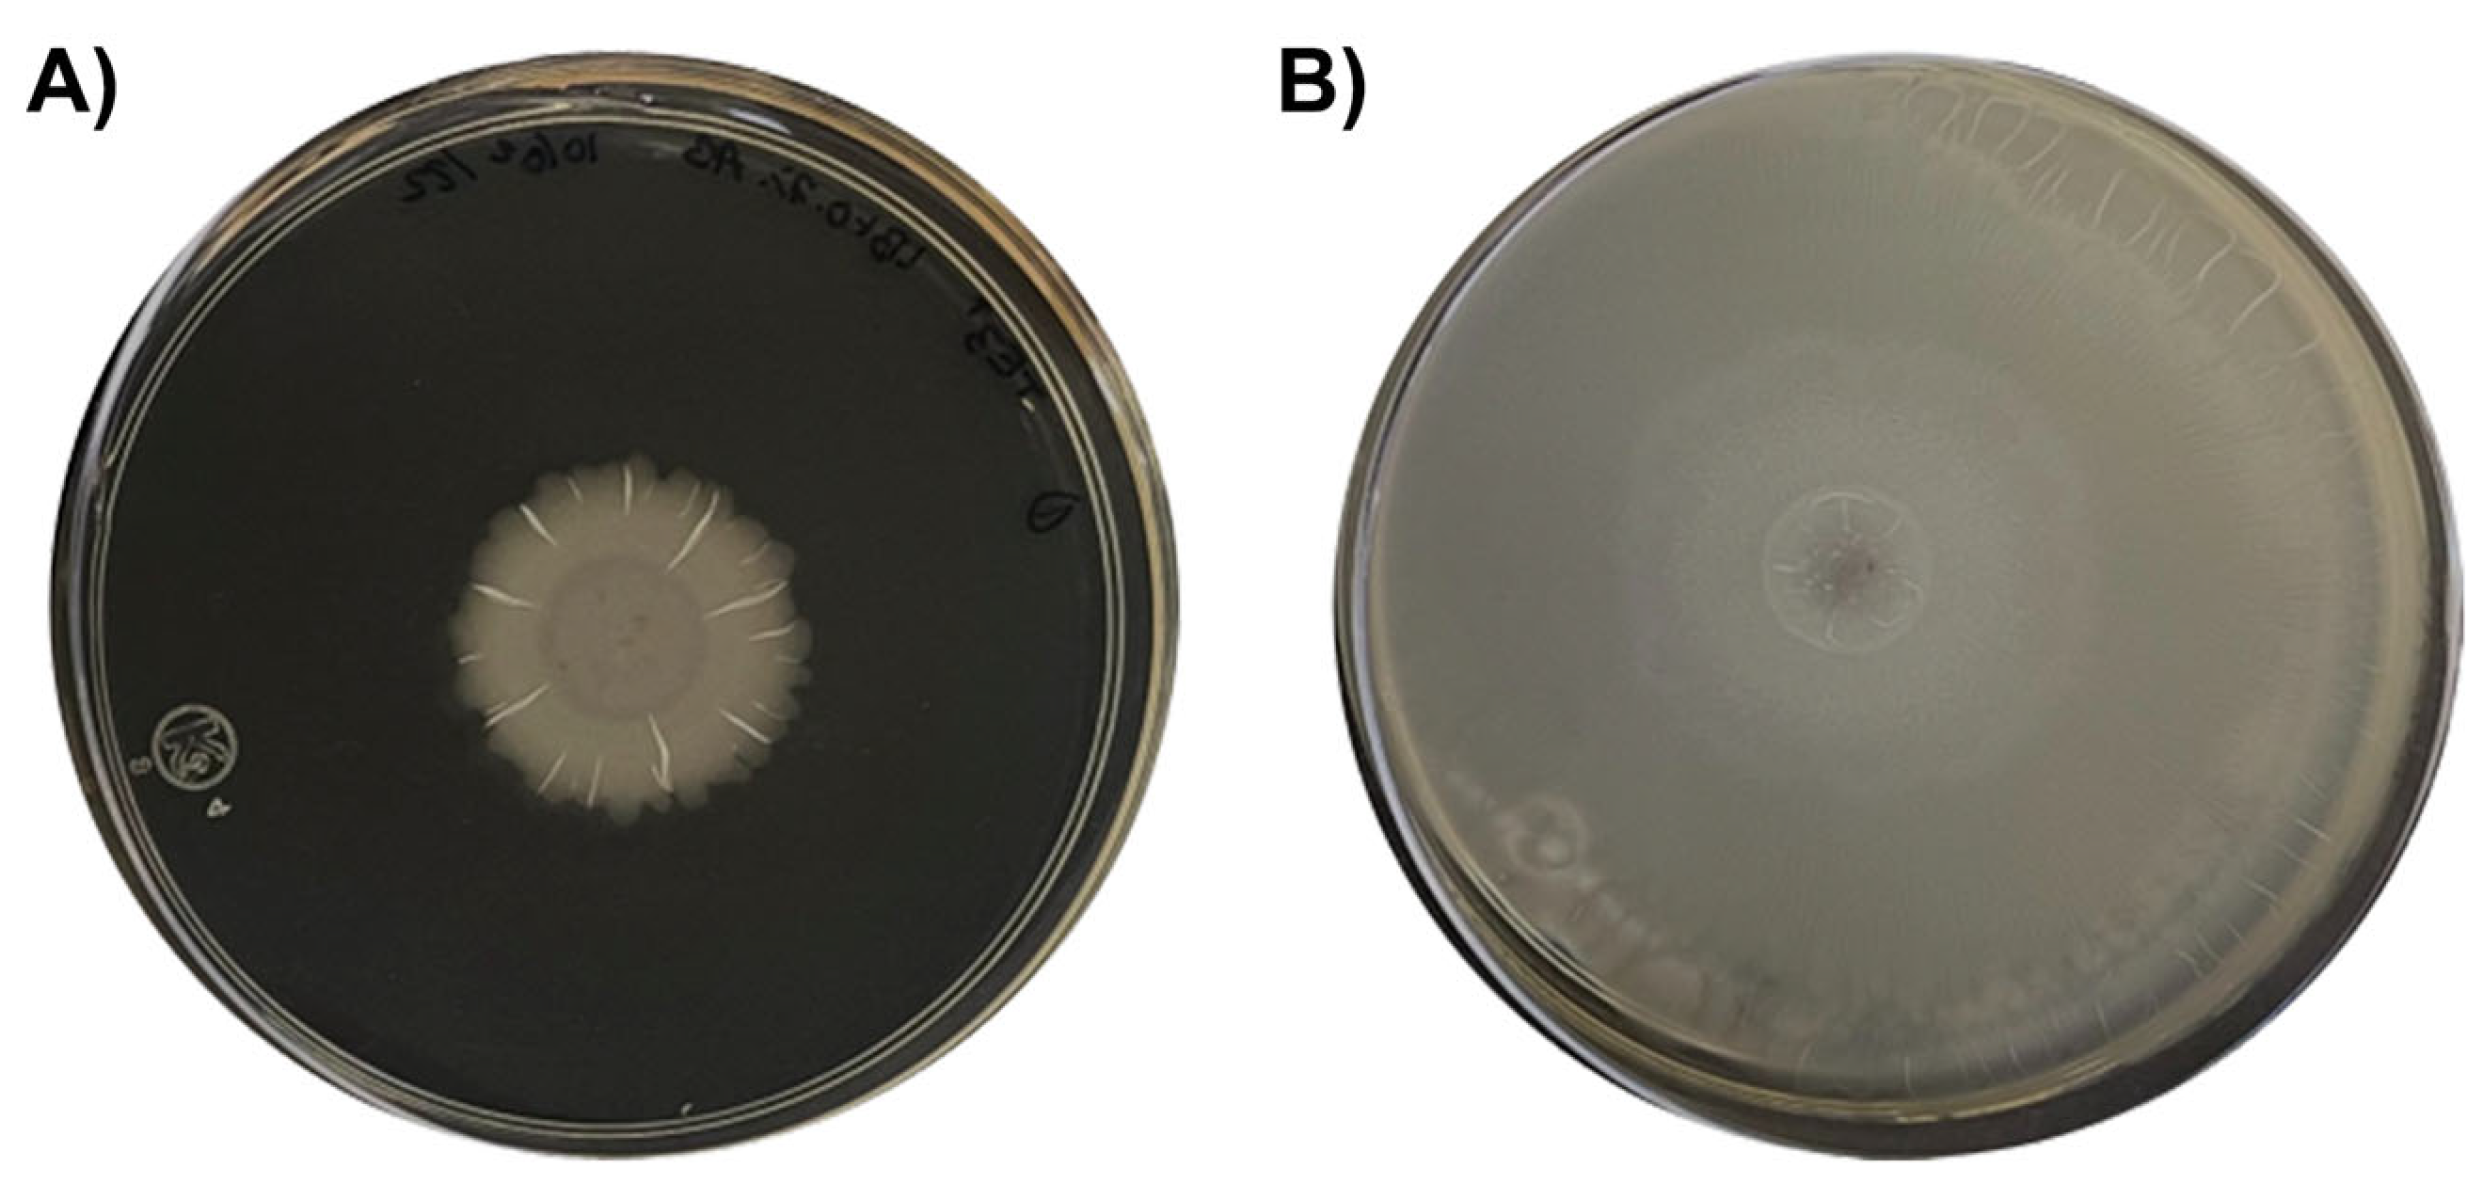
Plants 12 02419 g009 Plants 12 02419 g009

Bacillus cabrialesii: Five Years of Research on a Novel Species of Biological Control and Plant Growth-Promoting Bacteria
Abstract
1. Introduction
2. Isolation and First Approaches as Plant Growth Promoting and Biological Control Bacterium
3. Taxonomic Affiliation of Strain TE3T and Its Description as a Novel Bacillus Species
4. Bioprospecting Bacillus cabrialesii TE3T as an Effective Bioinoculant for Wheat
4.1. Bacillus cabrialesii TE3T Is a Plant Growth-Promoting Bacteria
4.2. Deciphering Potential Mechanisms of Biological Control through Omic Techniques
4.3. An Efficient Tool for Detection and Monitoring Bacillus cabrialesii TE3T
4.4. Bioformulation of Bacillus cabrialesii TE3T as a Bacterial Inoculant
4.5. Discovery of a Novel Subspecies of Bacillus cabrialesii
5. Current Research of Bacillus cabrialesii subsp. cabrialesii TE3T Developed at the LBRM-COLMENA
5.1. Bacillus cabrialesii subsp. cabrialesii TE3T as a Plant Growth Promotion
5.2. Bacillus cabrialesii subsp. cabrialesii TE3T as a Biological Control Agent
6. Research on Bacillus cabrialesii around the World
7. Conclusions and Perspectives
Author Contributions
Funding
Acknowledgments
Conflicts of Interest
References
- FAO, Food and Agriculture Organization. How to feed the World in 2050. In Proceedings of the Expert Meeting on How to Feed the World in 2050, Rome, Italy, 26 June 2009. [Google Scholar]
- Montoya-Martínez, A.C.; Parra-Cota, F.I.; Santos-Villalobos, S.d.L. Beneficial Microorganisms in Sustainable Agriculture: Harnessing Microbes’ Potential to Help Feed the World. Plants 2022, 11, 372. [Google Scholar] [CrossRef]
- Hyder, S.; Rizvi, Z.F.; de los Santos-Villalobos, S.; Santoyo, G.; Gondal, A.; Khalid, N.; Fatima, S.N.; Nadeem, M.; Rafique, K.; Rani, A. Applications of plant growth-promoting rhizobacteria for increasing crop production and resilience. J. Plant Nutr. 2023, 46, 2551–2580. [Google Scholar] [CrossRef]
- de los Santos-Villalobos, S.; Díaz-Rodríguez, A.M.; Ávila-Mascareño, M.F.; Martínez-Vidales, A.D.; Parra-Cota, F.I. COLMENA: A culture collection of native microorganisms for harnessing the agro-biotechnological potential in soils and contributing to food security. Diversity 2021, 13, 337. [Google Scholar] [CrossRef]
- García-Montelongo, A.M.; Montoya-Martínez, A.C.; Morales-Sandoval, P.H.; Parra-Cota, F.I.; de los Santos-Villalobos, S. Beneficial Microorganisms as a Sustainable Alternative for Mitigating Biotic Stresses in Crops. Stresses 2023, 3, 210–228. [Google Scholar] [CrossRef]
- Kumar, A.; Maurya, B.R.; Raghuwanshi, R.; Meena, V.S.; Islam, M.T. Co-inoculation with Enterobacter and Rhizobacteria on Yield and Nutrient Uptake by Wheat (Triticum aestivum L.) in the Alluvial Soil Under In-do-Gangetic Plain of India. J. Plant Growth Regul. 2017, 36, 608–617. [Google Scholar] [CrossRef]
- Zepeda, M.A.; Rodríguez, A.M.D.; Cardoso, R.; Muniz, M.C.; Astorga, R.T.; Linares, C.B.; Dos Anjos, R.M.; Velasco, H.; Vega, S.T.; Santos-Villalobos, S.D.L. Isótopos estables de compuestos específicos para estimar la redistribución del suelo por eventos erosivos. Agrociencia 2020, 54, 601–618. [Google Scholar] [CrossRef]
- Mabit, L.; Zapata, F.; Dercon, G.; Benmansour, M.; Bernard, C.; Walling, D.E. Assessment of soil erosion and sedimentation: The role of fallout radionuclides. In Guidelines for Using Fallout Radionuclides to Assess Erosion and Effectiveness of Soil Conservation Strategies; IAEA Publication: Vienna, Austria, 2014; pp. 3–28. [Google Scholar]
- Ayala-Zepeda, M.; de los Santos-Villalobos, S.; Bórquez-Olguín, R. Estrategia para la conservación del suelo. Cienc. Y Desarro. 2016, 1, 26–31. [Google Scholar]
- Cardenas, C.I.C.; Molina, L.X.Z.; Cancino, G.S.; Villalobos, S.D.L.S.; Anaya, E.R.; Díaz, I.F.C.; Ramirez, S.R. Utilización de microorganismos para una agricultura sostenible en México: Consideraciones y retos. Rev. Mex. Ciencias Agrícolas 2021, 12, 899–913. [Google Scholar] [CrossRef]
- WHO, World Health Organization. Pesticide Residues in Food. Available online: https://www.who.int/news-room/fact-sheets/detail/pesticide-residues-in-food (accessed on 5 April 2023).
- Villa-Rodríguez, E.; Parra-Cota, F.; Castro-Longoria, E.; López-Cervantes, J.; de los Santos-Villalobos, S. Bacillus subtilis TE3: A promising biological control agent against Bipolaris sorokiniana, the causal agent of spot blotch in wheat (Triticum turgidum L. subsp. durum). Biol. Control. 2019, 132, 135–143. [Google Scholar] [CrossRef]
- Villa-Rodriguez, E.; Moreno-Ulloa, A.; Castro-Longoria, E.; Parra-Cota, F.I.; de los Santos-Villalobos, S. Integrated omics approaches for deciphering antifungal metabolites produced by a novel Bacillus species, B. cabrialesii TE3T, against the spot blotch disease of wheat (Triticum turgidum L. subsp. durum). Microbiol. Res. 2021, 251, 126826. [Google Scholar] [CrossRef]
- Valenzuela-Aragon, B.; Parra-Cota, F.I.; Santoyo, G.; Arellano-Wattenbarger, G.L.; de los Santos-Villalobos, S. Plant-assisted selection: A promising alternative for in vivo identification of wheat (Triticum turgidum L. subsp. durum) growth-promoting bacteria. Plant Soil 2018, 435, 367–384. [Google Scholar] [CrossRef]
- Villa-Rodriguez, E.; Lugo-Enríquez, C.; de los Santos-Villalobos, S.; Parra-Cota, F.I.; Figueroa-López, P. First report of Cochliobolus sativus causing spot blotch on Durum Wheat (Triticum durum) in the Yaqui Valley, Mexico. Plant Dis. 2016, 100, 2329. [Google Scholar] [CrossRef]
- Acharya, K.; Dutta, A.K.A.K.; Pradhan, P. Bipolaris sorokiniana (Sacc.) Shoem.: The most destructive wheat fungal pathogen in the warmer areas. Aust. J. Crop Sci. 2011, 5, 1064–1071. [Google Scholar]
- Gupta, P.K.; Chand, R.; Vasistha, N.K.; Pandey, S.P.; Kumar, U.; Mishra, V.K.; Joshi, A.K. Spot blotch disease of wheat: The current status of research on genetics and breeding. Plant Pathol. 2018, 67, 508–531. [Google Scholar] [CrossRef]
- Sessitsch, A.; Brader, G.; Pfaffenbichler, N.; Gusenbauer, D.; Mitter, B. The contribution of plant microbiota to economy growth. Microb. Biotechnol. 2018, 11, 801–805. [Google Scholar] [CrossRef] [PubMed]
- Liu, Y.; Du, J.; Lai, Q.; Zeng, R.; Ye, D.; Xu, J.; Shao, Z. Proposal of nine novel species of the Bacillus cereus group. Int. J. Syst. Evol. Microbiol. 2017, 67, 2499–2508. [Google Scholar] [CrossRef]
- Wang, L.T.; Lee, F.L.; Tai, C.J.; Kasai, H. Comparison of gyrB gene sequences, 16S rRNA gene sequences and DNA-DNA hybridization in the Bacillus subtilis group. Int. J. Syst. Evol. Microbiol. 2007, 57, 1846–1850. [Google Scholar] [CrossRef]
- de los Santos Villalobos, S.; Robles, R.I.; Parra Cota, F.I.; Larsen, J.; Lozano, P.; Tiedje, J.M. Bacillus cabrialesii sp. nov., an endophytic plant growth promoting bacterium isolated from wheat (Triticum turgidum subsp. durum) in the Yaqui Valley, Mexico. Int. J. Syst. Evol. Microbiol. 2019, 69, 3939–3945. [Google Scholar] [CrossRef]
- Robles-Montoya, R.I.; Chaparro Encinas, L.A.; Parra-Cota, F.I.; De los Santos-Villalobos, S. Improving biometric traits of wheat seedlings with the inoculation of a consortium native of Bacillus . Rev. Mex. Cienc. Agrícolas 2020, 11, 229–235. [Google Scholar]
- Rojas Padilla, J.; Chaparro Encinas, L.A.; Robles Montoya, R.I.; De los Santos Villalobos, S. Growth promotion on wheat (Triticum turgidum L. subsp. durum) by co-inoculation of native Bacillus strains isolated from the Yaqui Valley, Mexico. Nov. Sci. 2020, 12, 24. [Google Scholar] [CrossRef]
- Chávez-Luzanía, R.A.; Montoya-Martínez, A.C.; Parra-Cota, F.I.; de los Santos-Villalobos, S. Pangenomes-identified singletons for designing specific primers to identify bacterial strains in a plant growth-promoting consortium. Mol. Biol. Rep. 2022, 49, 10489–10498. [Google Scholar] [CrossRef]
- Rojas-Padilla, J.; de-Bashan, L.E.; Parra-Cota, F.I.; Rocha-Estrada, J.; de los Santos-Villalobos, S. Microencapsulation of Bacillus Strains for Improving Wheat (Triticum turgidum subsp. durum) Growth and Development. Plants 2022, 11, 2920. [Google Scholar] [CrossRef]
- Berninger, T.; González López, Ó.; Bejarano, A.; Preininger, C.; Sessitsch, A. Maintenance and assessment of cell viability in the formulation of non-sporulating bacterial inoculants. Microb. Biotechnol. 2018, 11, 277–301. [Google Scholar] [CrossRef]
- De-Bashan, L.E.; Bashan, Y. Joint immobilization of plant growth-promoting bacteria and green microalgae in alginate beads as an experimental model for studying plant-bacterium interactions. Appl. Environ. Microbiol. 2008, 74, 6797–6802. [Google Scholar] [CrossRef] [PubMed]
- Gonzalez, E.J.; Hernandez, J.P.; de-Bashan, L.E.; Bashan, Y. Dry micro-polymeric inoculant of Azospirillum brasilense is useful for producing mesquite transplants for reforestation of degraded arid zones. Appl. Soil Ecol. 2018, 129, 84–93. [Google Scholar] [CrossRef]
- He, Y.; Wu, Z.; Tu, L.; Shan, C. Effect of encapsulated Pseudomonas putida Rs-198 strain on alleviating salt stress of cotton. J. Plant Nutr. 2017, 40, 1180–1189. [Google Scholar] [CrossRef]
- de los Santos-Villalobos, S.; Valenzuela-Ruiz, V.; Montoya-Martínez, A.C.; Parra-Cota, F.I.; Santoyo, G.; Larsen, J. Bacillus cabrialesii subsp. cabrialesii subsp. nov. and Bacillus cabrialesii subsp. tritici subsp. nov., plant growth-promoting bacteria and biological control agents isolated from wheat (Triticum turgidum subsp. durum) in the Yaqui Valley, Mexico. Int. J. Syst. Evol. Microbiol. 2023, 73, 005779. [Google Scholar] [CrossRef]
- Ibarra-Villarreal, A.L.; Villarreal-Delgado, M.F.; Parra-Cota, F.I.; Yepez, E.A.; Guzmán, C.; Gutierrez-Coronado, M.A.; Valdez, L.C.; Saint-Pierre, C.; Santos-Villalobos, S.d.L. Effect of a native bacterial consortium on growth, yield, and grain quality of durum wheat (Triticum turgidum L. subsp. durum) under different nitrogen rates in the Yaqui Valley, Mexico. Plant Signal Behav. 2023, 18, 2219837. [Google Scholar] [CrossRef] [PubMed]
- Ullah, H.; Santiago-Arenas, R.; Ferdous, Z.; Attia, A.; Datta, A. Improving water use efficiency, nitrogen use efficiency, and radiation use efficiency in field crops under drought stress: A review. In Advances in Agronomy; Elsevier: Amsterdam, The Netherlands, 2019; Volume 156, pp. 109–157. ISBN 9780128175989. [Google Scholar]
- Ayala-Zepeda, M. Impacto de La Inoculación de Un Consorcio Nativo de Bacillus Sobre La Eficiencia En El Uso Del 15N-Fertilizante Por El Trigo (Triticum turgidum L. subsp. durum) En El Valle Del Yaqui, México; Instituto Tecnológico de Sonora: Ciudad Obregón, Mexico, 2020. [Google Scholar]
- Ávila-Mascareño, M.F. Efecto de La Inoculación de Un Consorcio Bacteriano Nativo Sobre La Eficiencia Del Uso Del Agua Por El Cultivo de Trigo (Triticum turgidum L. subsp. durum), Bajo Diferentes Dosis de Fertilización Nitrogenada En El Valle Del Yaqui, México; Instituto Tecnológico de Sonora: Ciudad Obregón, Mexico, 2022. [Google Scholar]
- Orozco Meza, R.A. Efecto de los Metabolitos Precipitados de Bacillus Cabrialesii TE3T en el Control Biológico de Bipolaris Sorokiniana TPQ3, Agente Causal de la Mancha Borrosa del Trigo (Triticum turgidum L. subsp. durum); Instituto Tecnológico de Sonora: Ciudad Obregón, Mexico, 2022. [Google Scholar]
- Valenzuela Ruiz, V.; Parra Cota, F.I.; Santoyo, G.; Gómez Godínez, L.J.; Cira-Chávez, L.A.; de los Santos-Villalobos, S. Bacillus cabrialesii TE3T gene regulation associated with the biocontrol of Bipolaris sorokiniana. In Proceedings of the XXIV Congreso Internacional Y Xlix Congreso Nacional de la Sociedad Mexicana de Fitopatología; Ávila-Alistac, N., Mora-Aguilera, G., Eds.; Revista Mexicana de Fitopatología: Tepatitlán, México, 2022; p. S51. [Google Scholar]
- Mauch-Mani, B.; Baccelli, I.; Luna, E.; Flors, V. Defense Priming: An Adaptive Part of Induced Resistance. Annu. Rev. Plant Biol. 2017, 68, 485–512. [Google Scholar] [CrossRef]
- Pieterse, C.M.J.; Zamioudis, C.; Berendsen, R.L.; Weller, D.M.; Van Wees, S.C.M.; Bakker, P.A.H.M. Induced Systemic Resistance by Beneficial Microbes. Annu. Rev. Phytopathol. 2014, 52, 347–375. [Google Scholar] [CrossRef]
- García-Montelongo, A.M. Inducción de Resistencia Sistémica en Plantas de Trigo (Triticum turgidum L. subsp. durum) por el Filtrado Libre de Células de Bacillus Cabrialesii TE3T contra la mancha borrosa (Bipolaris sorokiniana); Instituto Tecnológico de Sonora: Ciudad Obregón, Mexico, 2023. [Google Scholar]
- Romero-Silva, J.H. Modulaciones del Microbioma Edáfico Por la Inoculación de Tres Consorcios Bacterianos Nativos al Cultivo de Chile Jalapeño en el Valle del Yaqui; Instituto Tecnológico de Sonora: Ciudad Obregón, Mexico, 2022. [Google Scholar]
- Zhou, L.; Song, C.; Li, Z.; Kuipers, O.P. Antimicrobial activity screening of rhizosphere soil bacteria from tomato and genome-based analysis of their antimicrobial biosynthetic potential. BMC Genom. 2021, 22, 29. [Google Scholar] [CrossRef]
- Zhou, L.; Song, C.; Muñoz, C.Y.; Kuipers, O.P. Bacillus cabrialesii BH5 Protects Tomato Plants Against Botrytis cinerea by Production of Specific Antifungal Compounds. Front. Microbiol. 2021, 12, 707609. [Google Scholar] [CrossRef] [PubMed]
- Kannan, C.; Mishra, D.; Rekha, G.; Maruthi, P.; Shaik, H.; Sundaram, R.M. Diversity analysis of antagonistic microbes against bacterial leaf and fungal sheath blight diseases of rice. Egypt. J. Biol. Pest Control. 2021, 31, 115. [Google Scholar] [CrossRef]
- Kannan, C.; Divya, M.; Rekha, G.; Barbadikar, K.M.; Maruthi, P.; Hajira, S.K.; Sundaram, R.M. Whole genome sequencing data of native isolates of Bacillus and Trichoderma having potential biocontrol and plant growth promotion activities in rice. Data Brief 2022, 41, 107923. [Google Scholar] [CrossRef] [PubMed]
- Mulk, S.; Wahab, A.; Yasmin, H.; Mumtaz, S.; El-Serehy, H.A.; Khan, N.; Hassan, M.N. Prevalence of Wheat Associated Bacillus spp. and Their Bio-Control Efficacy Against Fusarium Root Rot. Front. Microbiol. 2022, 12, 4097. [Google Scholar] [CrossRef]
- Naseer, A.; Andleeb, S.; Basit, A.; Abbasi, W.A.; Ejaz, S.; Ali, S.; Ali, N.M. Phylogenetic Illustration of Eisenia fetida Associated Vermi-bacteria Involved in Heavy Metals Remediation and Retaining Plant Growth Promoting Traits. J. Oleo Sci. 2022, 71, 1241–1252. [Google Scholar] [CrossRef] [PubMed]
- Rajer, F.U.; Samma, M.K.; Ali, Q.; Rajar, W.A.; Wu, H.; Raza, W.; Xie, Y.; Tahir, H.A.S.; Gao, X. Bacillus spp.-Mediated Growth Promotion of Rice Seedlings and Suppression of Bacterial Blight Disease under Greenhouse Conditions. Pathogens 2022, 11, 1251. [Google Scholar] [CrossRef]
- Dabiré, Y.; Somda, N.S.; Somda, M.K.; Compaoré, C.B.; Mogmenga, I.; Ezeogu, L.I.; Traoré, A.S.; Ugwuanyi, J.O.; Dicko, M.H. Assessment of probiotic and technological properties of Bacillus spp. isolated from Burkinabe Soumbala. BMC Microbiol. 2022, 22, 228. [Google Scholar] [CrossRef]
- Pawaskar, M.; Krishnan, K.P.; Kerkar, S. Salt-pan bacteria as potential plant growth promoters and their antagonistic activity to fungal pathogens of Capsicum annuum L. Curr. Sci. 2022, 123, 1129–1135. [Google Scholar] [CrossRef]

| Region | From | To | Bgc Type | Most Similar Known Cluster | Similarity |
|---|---|---|---|---|---|
| Region 1 | 243,786 | 284,655 | - | - | - |
| Region 2 | 332,686 | 354,098 | - | - | - |
| Region 3 | 427,815 | 506,704 | NRPS | Fengycin | 100% |
| Region 4 | 590,916 | 696,061 | NRPS | Bacillaene | 100% |
| Region 5 | 1,288,334 | 1,309,116 | - | - | - |
| Region 6 | 2,028,618 | 2,092,669 | NRPS | Surfactin | 86% |
| Region 7 | 2,222,460 | 2,263,350 | Other | Rhizocticin A | 93% |
| Region 8 | 2,740,198 | 2,781,616 | Other | Bacilysin | 100% |
| Region 9 | 2,784,080 | 2,805,691 | RiPP | Subtilosin A | 100% |
| Region 10 | 3,346,359 | 3,395,577 | NRPS | Bacillibactin | 100% |
| Region 11 | 4,047,919 | 4,078,040 | NRPS | Plipastatin | 38% |
Disclaimer/Publisher’s Note: The statements, opinions and data contained in all publications are solely those of the individual author(s) and contributor(s) and not of MDPI and/or the editor(s). MDPI and/or the editor(s) disclaim responsibility for any injury to people or property resulting from any ideas, methods, instructions or products referred to in the content. |
© 2023 by the authors. Licensee MDPI, Basel, Switzerland. This article is an open access article distributed under the terms and conditions of the Creative Commons Attribution (CC BY) license (https://creativecommons.org/licenses/by/4.0/).
Share and Cite
Figueroa-Brambila, K.M.; Escalante-Beltrán, A.; Montoya-Martínez, A.C.; Díaz-Rodríguez, A.M.; López-Montoya, N.D.; Parra-Cota, F.I.; de los Santos-Villalobos, S. Bacillus cabrialesii: Five Years of Research on a Novel Species of Biological Control and Plant Growth-Promoting Bacteria. Plants 2023, 12, 2419. https://doi.org/10.3390/plants12132419
Figueroa-Brambila KM, Escalante-Beltrán A, Montoya-Martínez AC, Díaz-Rodríguez AM, López-Montoya ND, Parra-Cota FI, de los Santos-Villalobos S. Bacillus cabrialesii: Five Years of Research on a Novel Species of Biological Control and Plant Growth-Promoting Bacteria. Plants. 2023; 12(13):2419. https://doi.org/10.3390/plants12132419
Chicago/Turabian StyleFigueroa-Brambila, Karem Ma., Alina Escalante-Beltrán, Amelia Cristina Montoya-Martínez, Alondra María Díaz-Rodríguez, Naomi Dayanna López-Montoya, Fannie Isela Parra-Cota, and Sergio de los Santos-Villalobos. 2023. "Bacillus cabrialesii: Five Years of Research on a Novel Species of Biological Control and Plant Growth-Promoting Bacteria" Plants 12, no. 13: 2419. https://doi.org/10.3390/plants12132419
APA StyleFigueroa-Brambila, K. M., Escalante-Beltrán, A., Montoya-Martínez, A. C., Díaz-Rodríguez, A. M., López-Montoya, N. D., Parra-Cota, F. I., & de los Santos-Villalobos, S. (2023). Bacillus cabrialesii: Five Years of Research on a Novel Species of Biological Control and Plant Growth-Promoting Bacteria. Plants, 12(13), 2419. https://doi.org/10.3390/plants12132419








